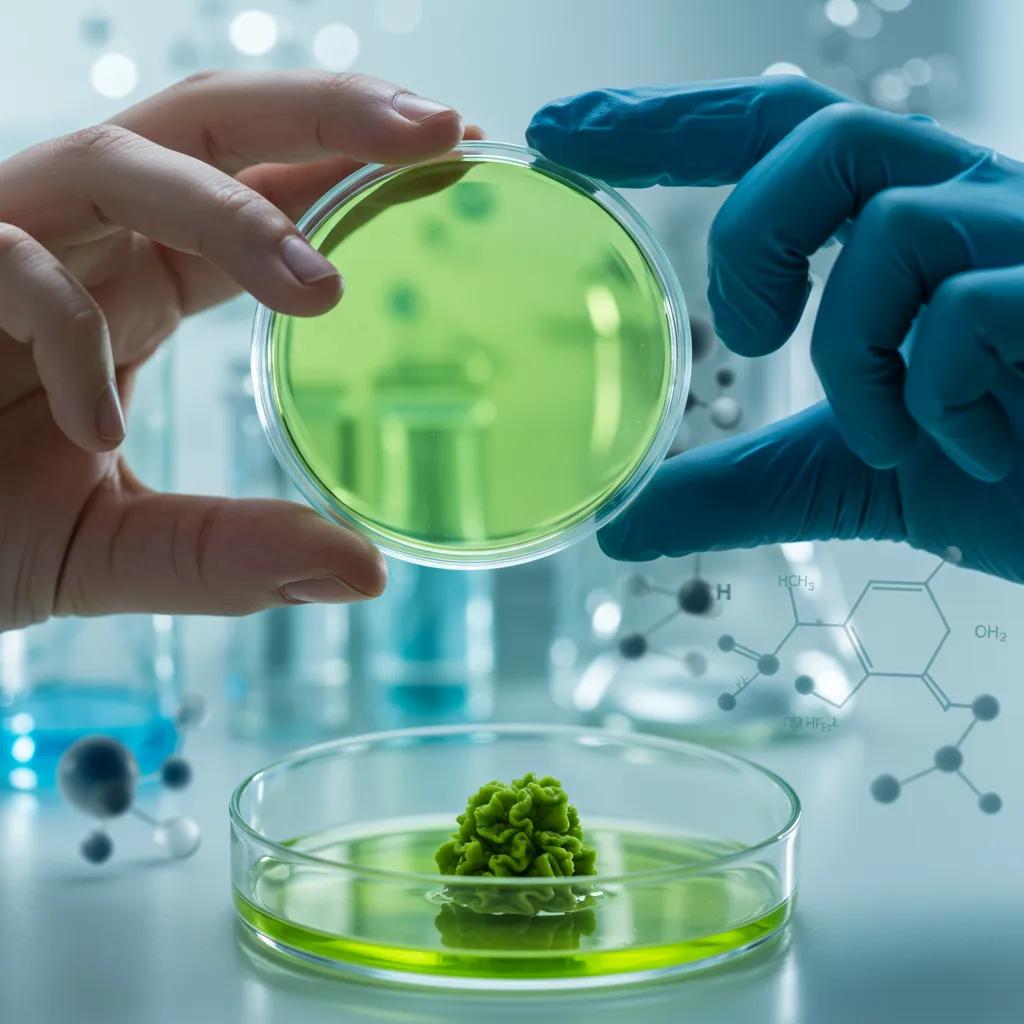
Scientist analyzing wasabi extract in a lab, illustrating NRF2 activation for antioxidant defense

Wasabi and Mitochondria: How Wasabi Supports Mitochondrial Health and Cellular Vitality

Mitochondria are the cellular powerhouses that produce ATP and coordinate redox signaling, and emerging research shows wasabi (Wasabia japonica) contains potent isothiocyanates that influence those systems. This article explains how wasabi-derived 6-MSITC and related isothiocyanates interact with NRF2, ALDH2, and NFκB pathways to protect mitochondria and support energy, cognition, and resilience. You'll discover basic mitochondrial biology, the molecular mechanisms by which wasabi compounds act, evidence levels from recent studies, and practical ways to apply these insights via diet and supplementation. Sections include mitochondrial function, NRF2 activation, ALDH2 detox pathways, NFκB modulation, a focused profile of 6-MSITC, and product-mapping for targeted mitochondrial support. Throughout, the content integrates clinically relevant concepts like oxidative stress and neuroprotection while highlighting high-quality NutraSabi formulations where appropriate.
What Is the Role of Mitochondria in Cellular Health and Energy?
Mitochondria generate ATP through oxidative phosphorylation while coordinating ROS signaling, metabolic intermediates, and apoptosis; their integrity therefore determines cellular energy and resilience. Dysfunction reduces ATP output, increases reactive aldehydes and ROS, and impairs repair pathways, which translates to fatigue, cognitive decline, and weakened immune responses. Understanding mitochondria as dynamic signaling hubs clarifies why botanicals that reduce oxidative load and support detox enzymes can preserve cellular energy. The next section breaks down how mitochondria produce ATP and manage oxidative byproducts to sustain tissue function.
How Do Mitochondria Produce Energy and Regulate Cell Function?
Mitochondria produce energy by oxidizing nutrients through the Krebs cycle and passing electrons down the electron transport chain to drive ATP synthase; this oxidative phosphorylation yields the majority of cellular ATP. During electron flow a controlled amount of reactive oxygen species (ROS) is generated, which acts as a signaling cue but also poses damage risk if unchecked. Mitochondria additionally regulate apoptosis and calcium buffering, linking bioenergetics to cell fate decisions. A clear grasp of these processes sets up why modulating antioxidant and detox pathways is central to mitochondrial support.
What Happens When Mitochondrial Function Declines?
When mitochondria fail to maintain efficient electron transport and ATP synthesis, cells accumulate ROS and reactive aldehydes that damage lipids, proteins, and DNA, impairing organ function. Clinically, mitochondrial decline manifests as decreased endurance, brain fog, slowed recovery, and increased susceptibility to stress and infection. At the molecular level, impaired mitochondria trigger inflammatory signaling and reduced repair enzyme activity, accelerating tissue aging and metabolic dysregulation. Recognizing these consequences highlights intervention targets such as antioxidant induction and aldehyde detoxification to preserve energy and cognition.
Why Is Mitochondrial Support Essential for Overall Wellness?
Supporting mitochondria improves systemic resilience because efficient ATP production underpins muscle performance, neuronal signaling, and immune cell function across organs. Interventions that lower oxidative burden, enhance phase II detox enzymes, or stabilize mitochondrial membranes can translate into better energy, clearer cognition, and slower functional decline with age. Lifestyle measures—nutrition, movement, sleep—work synergistically with compounds that activate protective pathways to maintain mitochondrial capacity. With that foundation, we can explore specific molecular mechanisms that wasabi targets to deliver mitochondrial protection.
Different aspects of mitochondrial dysfunction often present together:
- Loss of endurance and increased fatigue during activity.
- Cognitive slowing, poor memory recall, and mental fog.
- Slower recovery from infection or injury and higher inflammation.
| Mitochondrial Role | Primary Function | Consequence of Dysfunction |
|---|---|---|
| ATP production | Oxidative phosphorylation via ETC and ATP synthase | Energy deficit, fatigue, reduced organ performance |
| ROS signaling | Controlled ROS for signaling and adaptation | Oxidative damage, lipid peroxidation, aldehyde formation |
| Apoptosis regulation | Release of cytochrome c and caspase activation | Excess cell death or impaired clearance |
| Metabolic integration | TCA cycle & metabolite synthesis | Metabolic inflexibility, insulin/resilience issues |
This table summarizes core mitochondrial functions and what deteriorates when mitochondrial health declines, clarifying the mechanisms that botanical interventions aim to protect.
How Does Wasabi Activate the NRF2 Pathway for Antioxidant Defense?
NRF2 is a transcription factor that, when released from Keap1, translocates to the nucleus and induces phase II antioxidant and detox genes to enhance cellular defense. Electrophilic isothiocyanates like 6-MSITC react with Keap1 cysteines, stabilizing NRF2 and raising expression of glutathione synthesis enzymes and other cytoprotective proteins. Activating NRF2 reduces oxidative damage within mitochondria, supports redox balance, and lowers reactive aldehyde burden, all of which preserve ATP production. The following subsections define NRF2 in more detail and explain how wasabi’s chemistry triggers this master regulator.
What Is the NRF2 Pathway and Its Importance in Cellular Protection?
NRF2 governs a network of antioxidant and phase II detoxification genes via antioxidant response elements (AREs) in target promoters, enhancing glutathione production and xenobiotic clearance. Under basal conditions NRF2 is sequestered by Keap1 and targeted for degradation; modifying Keap1 cysteines releases NRF2 to drive transcription of enzymes that neutralize ROS and repair oxidative damage. This pathway therefore acts as a frontline defense that reduces mitochondrial oxidative stress and supports cellular repair. Boosting NRF2 activity is a validated strategy to reduce age-related oxidative decline and improve resilience.
How Does Wasabi’s 6-MSITC Compound Trigger NRF2 Activation?
6-MSITC is an electrophilic isothiocyanate formed from wasabi glucosinolates via myrosinase activity and it can covalently modify sensor cysteines on Keap1, triggering NRF2 release and nuclear translocation. Preclinical studies show isothiocyanates increase ARE-driven gene expression, elevating enzymes like glutathione-S-transferases and NAD(P)H:quinone oxidoreductase, which collectively reduce intracellular ROS and aldehyde stress. This biochemical interaction explains how dietary or supplemental wasabi components can strengthen mitochondrial antioxidant defenses. Understanding bioavailability and formulation is important because processing influences 6-MSITC stability and delivery.
Research indicates that 6-MSITC, a key component of wasabi, activates the NRF2 pathway, which is crucial for cellular defense against oxidative and lipid stress.
Wasabi's 6-MSITC Activates AMPK and Nrf2 for Antioxidant and Lipid Stress Protection
6-(Methylsulfinyl) hexyl isothiocyanate (6-MSITC) is an active ingredient present in Wasabi, which is a popular pungent spice used in Japanese cuisine. Our previous studies suggested that the primary antioxidant activity of 6-MSITC may link to other biological activity. This study aimed to clarify how the antioxidant activity of 6-MSITC contributes to preventing overloaded lipid stress in hepatic cell model. HepG2 cells were treated with 6-MSITC at defined concentrations and times in normal medium or in combined fatty acids (CFA) medium, and the targeted proteins were detected by Western blotting. The kinetic data revealed that 6-MSITC activated AMP-activated protein kinase α (AMPKα) and nuclear factor (erythroid-derived 2) like 2 (Nrf2), and then enhanced the protein expression of Forkhead box protein O1 (FOXO1) and Sirtuin1 as well as that of the Nrf2 target proteins, NAD(P)H:quinone oxidoreductase 1 (NQO1) and heme oxygenase (HO-1). Furthermore, lipid metabolic stress was mi
Involvement of AMP-activated Protein Kinase α/Nuclear Factor (Erythroid-derived 2) Like 2-iniatived Signaling Pathway in Cytoprotective Effects of Wasabi 6 …, Z He, 2022
What Are the Anti-Aging and Immune Benefits of NRF2 Activation by Wasabi?
By inducing NRF2, wasabi-derived compounds lower oxidative damage to mitochondrial proteins and lipids, which supports sustained ATP output and reduces cellular senescence signals that drive aging. NRF2 activation also modulates immune cell redox balance, enhancing cellular resilience during inflammatory challenges and improving repair functions. These effects translate into potential benefits for cognitive longevity, cardiovascular protection, and improved recovery from oxidative insults. Consistent intake of high-quality wasabi-derived bioactives contributes to long-term mitochondrial and immune health.
Wasabi-driven NRF2 activation yields several measurable benefits:
- Enhanced Antioxidant Capacity: Upregulation of glutathione and phase II enzymes protects mitochondria.
- Reduced Oxidative Damage: Lower lipid peroxidation and protein oxidation preserve mitochondrial function.
- Improved Cellular Resilience: Cells respond better to metabolic and inflammatory stress.
These NRF2-mediated actions create a biochemical environment favorable for sustained cellular energy and repair.
In What Ways Does Wasabi Support the ALDH2 Pathway for Detoxification?
ALDH2 is a mitochondrial enzyme that metabolizes toxic aldehydes generated from lipid peroxidation, and its activity preserves mitochondrial proteins and membranes from irreversible damage. Compounds that reduce aldehyde formation or that indirectly maintain ALDH2 function thereby protect respiratory chain components and ATP production. Wasabi’s induction of antioxidant enzymes via NRF2 and its reduction of ROS indirectly lower aldehyde burden and can preserve ALDH2’s effectiveness. The next subsections define ALDH2’s role and outline how wasabi compounds may enhance aldehyde detoxification to support cellular resilience.
What Is ALDH2 and Its Role in Cellular Detoxification?
ALDH2 catalyzes the oxidation of reactive aldehydes such as 4-hydroxynonenal (4-HNE) into less reactive acids, preventing crosslinking of proteins and lipids that would impair mitochondrial membranes and enzyme function. Located in the mitochondrial matrix, ALDH2 activity directly influences respiratory chain integrity and energy metabolism by limiting aldehyde-mediated damage. When ALDH2 function declines, aldehyde accumulation accelerates oxidative injury and mitochondrial inefficiency, contributing to cellular dysfunction. Maintaining ALDH2 activity is therefore central to mitochondrial preservation and healthy aging.
How Does Wasabi Enhance ALDH2 Activity to Promote Cellular Resilience?
Wasabi does not necessarily act as a direct ALDH2 enzyme activator in humans, but by inducing NRF2-driven antioxidant enzymes and lowering oxidative stress, it reduces the production of reactive aldehydes that burden ALDH2. Preclinical data suggest isothiocyanates diminish lipid peroxidation and aldehyde formation, indirectly decreasing ALDH2 workload and preserving enzyme capacity. This indirect support helps maintain mitochondrial protein function and respiratory efficiency under stress. Consequently, wasabi’s combined antioxidant and anti-inflammatory actions contribute to aldehyde detox balance.
How Does ALDH2 Support Mitochondrial Health and Energy Metabolism?
By clearing reactive aldehydes ALDH2 prevents modification of mitochondrial respiratory complexes and cardiolipin, a lipid essential for electron transport chain stability, thereby supporting efficient ATP generation. Preservation of ALDH2 function reduces oxidative damage to mitochondrial DNA and proteins, lowering the rate of dysfunction that leads to energy deficits. Healthy ALDH2 activity thus sustains cellular energy balance, aids recovery after oxidative insults, and limits pro-inflammatory signaling that further impairs mitochondria. Next, we examine how modulating inflammatory pathways complements these detox efforts.
Key aspects of ALDH2-related mitochondrial protection include:
- Prevention of aldehyde-induced protein crosslinking.
- Maintenance of lipid membrane integrity critical for ETC function.
- Reduction of secondary inflammatory signals that worsen mitochondrial damage.
| Pathway | Function | Result of Preservation |
|---|---|---|
| ALDH2 detoxification | Oxidizes reactive aldehydes in mitochondria | Reduced protein/lipid damage and preserved respiration |
| NRF2 antioxidant induction | Increases glutathione and phase II enzymes | Lower aldehyde production and oxidative load |
| Mitochondrial repair | Protects ETC components | Sustained ATP production and resilience |
This table links detox and antioxidant pathways to mitochondrial outcomes, illustrating how complementary mechanisms protect cellular energy systems.
How Does Wasabi Modulate NFκB to Reduce Inflammation and Support Mitochondria?
NFκB is a central transcription factor that drives pro-inflammatory cytokine expression, and chronic NFκB activation elevates ROS and impairs mitochondrial function through sustained inflammatory signaling. Isothiocyanates from wasabi can interfere with NFκB activation steps—such as upstream kinase signaling or IκB degradation—thereby lowering cytokine release and inflammatory burden. Reduced NFκB signaling decreases mitochondrial oxidative pressure and preserves bioenergetic function, creating a feedback loop where lower inflammation supports cleaner mitochondrial respiration. The subsections below define NFκB and explain how wasabi-derived compounds attenuate its harmful effects.
What Is the NFκB Pathway and Its Role in Inflammation?
NFκB is a family of transcription factors that, when activated by stress or immune signals, translocate to the nucleus to increase expression of cytokines, chemokines, and adhesion molecules that orchestrate inflammation. While acute NFκB signaling is protective, chronic activation promotes sustained inflammation, ROS production, and tissue damage that compromise mitochondrial function. Understanding NFκB’s role clarifies why inhibitors of prolonged NFκB activation can reduce mitochondrial wear-and-tear and improve cellular energy balance. This sets the stage for how dietary compounds can impact inflammatory signaling.
How Does Wasabi Inhibit NFκB to Manage Chronic Inflammation?
Isothiocyanates in wasabi act through multiple nodes to blunt NFκB signaling, including modulation of upstream kinases, stabilization of IκB, and redox-sensitive inhibition of transcriptional activation; these actions have been demonstrated in preclinical models. By dampening NFκB activity, wasabi reduces the production of pro-inflammatory cytokines that would otherwise elevate ROS and damage mitochondrial components. This anti-inflammatory effect complements NRF2-driven antioxidant defense, creating coordinated protection for mitochondria and cellular metabolism. Practical implications include lower chronic inflammation and improved mitochondrial efficiency over time.
Research highlights that sustained activation of the NF-κB signaling pathway can significantly drive mitochondrial dysfunction and negatively impact insulin sensitivity.
NF-κB Signaling Drives Mitochondrial Dysfunction and Impairs Insulin Sensitivity
1. Sustained nutrient (fuel) excess, as occurs during obesity and diabetes, has been linked to increased inflammation, impaired mitochondrial homeostasis, lipotoxicity, and insulin resistance in skeletal muscle. Precisely how mitochondrial dysfunction is initiated and whether it contributes to insulin resistance in this tissue remains a poorly resolved issue. Herein, we examine the contribution that an increase in proinflammatory NFkB signalling makes towards regulation of mitochondrial bioenergetics, morphology, and dynamics and its impact upon insulin action in skeletal muscle cells subject to chronic fuel (glucose and palmitate) overloading. We show sustained nutrient excess of L6 myotubes promotes activation of the IKKβ-NFkB pathway (as judged by a six-fold increase in IL-6 mRNA expression; an NFkB target gene) and that this was associated with a marked reduction in mitochondrial respiratory capacity (>50%), a three-fold increase in mitochondrial fragmentation and 2.5-fold increase in mitophagy. Under these circumstances, we also noted a reduction in the mRNA and protein abundance of PGC1α and that of key mitochondrial components (SDHA, ANT-1, UCP3, and MFN2) as well as an increase in cellular ROS and impaired insulin action in myotubes. Strikingly, pharmacological or genetic repression of NFkB activity ameliorated disturbances in mitochondrial respiratory function/morphology, attenuated loss of SDHA, ANT-1, UCP3, and MFN2 and mitigated the increase in ROS and the associated reduction in myotube insulin sensitivity. Our findings indicate that sustained oversupply of metabolic fuel to skeletal muscle cells induces heightened NFkB signalling and that this serves as a critical driver for disturbances in mitochondrial function and morphology, redox status, and insulin signalling.
Proinflammatory NFkB signalling promotes mitochondrial dysfunction in skeletal muscle in response to cellular fuel overloading, RB Nisr, 2019
Why Is NFκB Modulation Important for Mitochondrial and Immune Health?
Controlling NFκB prevents the chronic inflammatory state that leads to persistent mitochondrial dysfunction, reduced ATP output, and impaired immune cell energetics. Balanced NFκB activity supports immune responses while avoiding excessive cytokine-driven oxidative stress that exhausts mitochondrial repair systems. Together with NRF2 induction and ALDH2 maintenance, NFκB modulation forms a triad of protective mechanisms that sustain cellular energy, reduce age-related decline, and preserve cognitive and cardiovascular function. These interlocking pathways show why wasabi’s multi-target effects are relevant for whole-body resilience.
Wasabi’s modulation of NFκB delivers practical benefits:
- Lower chronic inflammation: Reduced cytokine expression lessens systemic oxidative pressure.
- Preserved mitochondrial function: Less inflammatory signaling protects ETC complexes.
- Improved immune balance: Lower inflammatory tone supports efficient immune energetics.
What Are the Unique Health Benefits of 6-MSITC, Wasabi’s Key Bioactive Compound?

6-MSITC (6-methylsulfinylhexyl isothiocyanate) is a lipophilic isothiocyanate derived from glucosinolate hydrolysis in authentic wasabi rhizome; it combines electrophilic NRF2 activation with anti-inflammatory NFκB modulation and indirect ALDH2 support. The compound’s chemical profile allows it to engage redox sensor proteins and reduce lipid peroxidation, providing neuroprotective, cardiovascular, and metabolic benefits in preclinical and emerging clinical studies. Practical considerations include stability during processing and the need for formulations that preserve myrosinase-mediated conversion for maximal 6-MSITC bioavailability. The next subsections describe origin, cognitive effects, and cardiovascular implications.
What Is 6-MSITC and How Is It Derived from Wasabi?
6-MSITC forms when wasabi glucosinolates are enzymatically converted by myrosinase following tissue disruption; this hydrolysis yields the active isothiocyanate responsible for many of wasabi’s biological effects. Processing methods and storage conditions determine myrosinase activity and therefore 6-MSITC yield, making sourcing and formulation critical for delivering consistent bioactive levels. Analytical methods quantify 6-MSITC concentration in rhizome powder or extracts, informing dose design for supplements. Understanding derivation underscores why authentic wasabi sourcing matters for efficacy.
How Does 6-MSITC Support Brain Health and Cognitive Vitality?
6-MSITC supports brain health by lowering neuroinflammation via NFκB inhibition and boosting antioxidant defenses through NRF2 activation, which together reduce oxidative damage to neurons and mitochondria. These mechanisms translate in models to improved synaptic function, reduced microglial activation, and preserved mitochondrial energetics that underlie cognitive processes like memory and attention. While human trials are still emerging, the mechanistic profile of 6-MSITC suggests it can contribute to cognitive resilience when applied consistently alongside lifestyle measures. The following section connects these brain benefits to cardiovascular and energy outcomes.
What Are the Cardiovascular and Cellular Energy Benefits of 6-MSITC?
6-MSITC may support endothelial health by reducing oxidative stress and inflammation that impair nitric oxide signaling and vascular function, thereby preserving tissue perfusion and mitochondrial oxygen delivery. By lowering lipid peroxidation and protecting mitochondrial membranes in cardiac and vascular tissues, 6-MSITC helps maintain efficient ATP generation and metabolic flexibility. These indirect effects on energy metabolism can support physical endurance and recovery, linking vascular protection to whole-body bioenergetics. Together, cardiovascular and mitochondrial benefits form a practical rationale for including wasabi-derived bioactives in wellness strategies.
| Attribute | Mechanism | Expected Benefit |
|---|---|---|
| NRF2 activation | Electrophilic modification of Keap1 cysteines | Increased antioxidant enzymes, reduced ROS |
| NFκB modulation | Inhibition of upstream inflammatory signaling | Lower cytokine production, less mitochondrial stress |
| Aldehyde reduction | Reduced lipid peroxidation | Preservation of mitochondrial proteins and membranes |
This table clarifies how 6-MSITC’s molecular actions map to cellular and systemic benefits relevant to energy and cognition.
For readers interested in products that concentrate 6-MSITC and authentic wasabi rhizome powder, NutraSabi offers formulations designed for mitochondrial and cellular support. NutraSabi emphasizes authentic Wasabia japonica sourcing, scientifically-backed formulations, and comprehensive third-party testing to ensure product consistency. These product options provide practical ways to access concentrated wasabi bioactives for ongoing mitochondrial maintenance while upholding our science-first approach.
Which NutraSabi Wasabi Products Deliver Targeted Mitochondrial and Cellular Support?
NutraSabi’s product lineup focuses on authentic wasabi rhizome derivatives standardized for bioactive delivery to support NRF2, ALDH2, and NFκB-related outcomes. Product formulations include NutraSabi™ Capsules for concentrated rhizome powder, NutraSabi™ Powder for flexible dietary use, and GinSabi™ Capsules combining ginseng with wasabi for adaptogenic and mitochondrial support. Mapping each product to its active constituents and targeted pathways clarifies how to choose a formulation based on goals like cognitive resilience, energy, or daily detox support. The subsections below explain product-to-pathway relationships and usage contexts.
How Do NutraSabi™ Capsules Promote Mitochondrial Health and Cognitive Function?
NutraSabi™ Capsules deliver standardized wasabi rhizome powder concentrated for consistent 6-MSITC content, aiming to support NRF2 activation and reduce neuroinflammatory signaling that impairs mitochondrial efficiency. Capsules provide a convenient, measured dose for daily use and are positioned for consumers seeking sustained mitochondrial and cognitive maintenance. NutraSabi’s formulation approach emphasizes authentic sourcing and third-party testing to ensure predictable bioactive levels and to facilitate consistent outcomes over time. For many users, capsules are a practical form to integrate wasabi’s mitochondrial benefits into a daily routine.
What Are the Energy and Cognition Benefits of GinSabi™ Capsules?
GinSabi™ Capsules combine ginseng with wasabi to harness adaptogenic energy support alongside antioxidant and anti-inflammatory signaling from wasabi bioactives. The blend targets both stress resilience and mitochondrial protection—ginseng’s adaptogenic properties support sustained energy and cognitive focus, while wasabi-derived 6-MSITC contributes NRF2 and NFκB modulation to protect cellular energetics. This synergistic pairing aims to enhance daytime performance and recovery by supporting metabolic flexibility and neuronal resilience. Consumers seeking combined adaptogenic and mitochondrial benefits may find this blend particularly relevant.
How Does NutraSabi™ Wasabi Powder Support Overall Wellness?
NutraSabi™ Wasabi Powder offers culinary and supplemental flexibility, allowing precise control over dose and timing while delivering authentic wasabi rhizome compounds that generate 6-MSITC when activated. Powder use enables incorporation into meals or beverages to support daily antioxidant and detox pathways, making it suitable for those who prefer versatile intake methods. Powder quality and handling influence myrosinase activity and 6-MSITC yield, so NutraSabi emphasizes sourcing and testing to maintain potency. For integrative wellness, powder provides a practical route to regular intake and mitochondrial support.
| Product | Active Ingredient / Form | Targeted Pathways / Claimed Benefits |
|---|---|---|
| NutraSabi™ Capsules | Standardized wasabi rhizome powder (6-MSITC-rich) | NRF2 activation, NFκB modulation; cognitive and mitochondrial support |
| GinSabi™ Capsules | Ginseng + wasabi blend | Adaptogenic energy, stress resilience; antioxidant signaling and cognitive focus |
| NutraSabi™ Powder | Authentic wasabi rhizome powder | Flexible dosing for daily antioxidant and detox support; culinary/supplement use |
This table links each product to its mechanisms and typical consumer benefits to aid selection.
NutraSabi’s emphasis on authentic Wasabia japonica lineage, scientifically-informed blends, and third-party testing supports product reliability, while the product choices allow consumers to match form and function to their mitochondrial health goals.
What Common Questions Do Consumers Have About Wasabi and Mitochondrial Health?
Short, direct answers address practical expectations: wasabi supports mitochondrial defense primarily through NRF2 induction and NFκB inhibition, benefits are often gradual and cumulative, and product quality determines delivered 6-MSITC. The following H3 items provide concise guidance on benefits, mechanisms, likely outcomes, and usage recommendations that align with current research and product formulations.
What Are the Main Health Benefits of Wasabi for Mitochondria?
Wasabi supports mitochondria by activating NRF2-driven antioxidant defenses, reducing pro-inflammatory NFκB signaling, and indirectly preserving ALDH2-mediated aldehyde detoxification to limit mitochondrial damage. These combined actions lower oxidative burden, protect respiratory chain components, and support ATP production, which manifests as improved cellular energy, clearer cognition, and enhanced recovery. Regular intake of high-quality wasabi derivatives can therefore contribute to long-term mitochondrial resilience when paired with healthy lifestyle habits. The connection between mechanism and outcome makes wasabi a strategic botanical for cellular vitality.
How Does Wasabi Help Reduce Oxidative Stress and Inflammation?
Wasabi’s isothiocyanates, notably 6-MSITC, trigger NRF2 to increase antioxidant enzyme production and interfere with NFκB-mediated inflammatory gene expression, thereby lowering both ROS and cytokine-driven inflammation. This double action reduces lipid peroxidation and aldehyde production, minimizing damage to mitochondrial membranes and proteins. The practical implication is less oxidative wear on energy systems and a cellular environment more conducive to efficient ATP generation. These mechanisms explain observable benefits like improved endurance and reduced brain fog when sustained use is applied.
Can Wasabi Improve Memory, Energy, and Immune Function?
Evidence suggests wasabi-derived compounds can support memory and energy indirectly by protecting neuronal and mitochondrial function, and they can modulate immune responses by lowering chronic inflammatory signaling; however, human outcomes depend on dose, product quality, and consistency. Preclinical models show neuroprotective and metabolic benefits, and emerging clinical data supports cautious optimism for cognitive and energetic improvements over weeks to months. Combining supplementation with sleep, exercise, and nutrition enhances the likelihood of noticeable benefits. Consumers should set realistic timeframes and monitor outcomes.
How Should I Use Wasabi Supplements for Best Mitochondrial Support?
Use standardized, third-party-tested products and follow label dosing to ensure consistent intake of wasabi bioactives, and consider forms that preserve myrosinase activity for optimal 6-MSITC generation; pair supplementation with antioxidant-rich diet, regular exercise, and adequate sleep for synergistic effects. Start with recommended daily doses and evaluate effects over 8–12 weeks, adjusting with professional guidance if you take medications or have underlying conditions. Look for formulations that state authentic Wasabia japonica sourcing and third-party testing for potency and purity. Proper product selection and lifestyle integration maximize mitochondrial benefits.
For practical guidance, consider these consumer tips:
- Choose products standardized for wasabi rhizome content and tested for consistency.
- Combine supplementation with lifestyle measures (sleep, movement, diet) for best results.
- Consult a healthcare provider if on medications or with health conditions before starting supplements.
NutraSabi’s product options—NutraSabi™ Capsules, GinSabi™ Capsules, and NutraSabi™ Powder—are formulated to meet these criteria, emphasizing authentic Wasabia japonica sourcing, scientifically-backed blends, and comprehensive third-party testing to support mitochondrial and cellular health.
NutraSabi is the Health and Wellness Division of Real Wasabi, USA and positions its formulations around authentic sourcing and scientific validation; third-party testing and product standardization are highlighted to ensure consistent delivery of wasabi bioactives for mitochondria-focused outcomes. If you seek targeted mitochondrial support from wasabi-based supplements, NutraSabi’s capsules and powders offer practical, tested options to integrate into a comprehensive wellness plan.
Frequently Asked Questions
What are the potential side effects of consuming wasabi supplements?
While wasabi is generally safe for most people, excessive consumption can lead to gastrointestinal discomfort, including nausea or stomach upset. Some individuals may also experience allergic reactions, particularly if they have sensitivities to other cruciferous vegetables. It's advisable to start with small amounts and monitor your body's response. If you have underlying health conditions or are taking medications, consult a healthcare professional before adding wasabi supplements to your routine to avoid any adverse interactions.
How does wasabi compare to other antioxidant-rich foods?
Wasabi is unique among antioxidant-rich foods due to its high concentration of isothiocyanates, particularly 6-MSITC, which activate the NRF2 pathway for cellular protection. While other foods like berries, green tea, and dark leafy greens also provide antioxidants, wasabi's specific compounds offer distinct benefits for mitochondrial health and inflammation reduction. Incorporating a variety of antioxidant sources, including wasabi, can enhance overall health by providing a broader spectrum of protective nutrients.
Can wasabi help with weight management or metabolic health?
Wasabi may support weight management indirectly by enhancing metabolic health through its antioxidant properties and potential to improve mitochondrial function. By reducing oxidative stress and inflammation, wasabi can help optimize energy metabolism, which is crucial for maintaining a healthy weight. However, it should be part of a balanced diet and active lifestyle for effective weight management. More research is needed to fully understand its role in metabolic health, but its inclusion in a healthy diet is beneficial.
How often should I consume wasabi for optimal health benefits?
For optimal health benefits, incorporating wasabi into your diet several times a week is recommended. This can be achieved through culinary use or supplementation. Regular intake allows for consistent activation of protective pathways like NRF2 and ALDH2, which support mitochondrial health. However, individual needs may vary, so it's best to start with moderate amounts and adjust based on personal health goals and dietary preferences. Consulting a healthcare provider can help tailor the approach to your specific needs.
Are there specific populations that should avoid wasabi?
Individuals with certain health conditions, such as gastrointestinal disorders or those who are pregnant, may want to limit their intake of wasabi due to its potential to irritate the digestive system. Additionally, people with allergies to cruciferous vegetables should avoid wasabi. If you have any concerns about how wasabi might affect your health, especially if you are on medication or have chronic health issues, it's advisable to consult a healthcare professional before incorporating it into your diet.
What is the best way to store wasabi supplements to maintain potency?
To maintain the potency of wasabi supplements, store them in a cool, dry place away from direct sunlight and moisture. Keeping them in their original packaging, tightly sealed, can help protect against degradation. If the product requires refrigeration, ensure it is stored at the recommended temperature. Always check the expiration date and follow any specific storage instructions provided by the manufacturer to ensure you receive the full benefits of the active compounds.
Conclusion
Integrating wasabi into your diet can significantly enhance mitochondrial health by activating key protective pathways like NRF2, ALDH2, and NFκB. These mechanisms work together to reduce oxidative stress, improve energy production, and support cognitive function, making wasabi a valuable addition to your wellness routine. For optimal results, consider exploring NutraSabi's range of high-quality wasabi supplements designed for targeted mitochondrial support. Start your journey towards better cellular vitality today by choosing the right wasabi product for your needs.
About
Key Takeaways:
Unique 6-MSITC and Other ITC's Activate Healing
Pair text with an image to focus on your chosen product, collection, or blog post. Add details on availability, style, or even provide a review.
Activates Nrf2 (HO-1, NQO1, glutathione enzymes).
Pair text with an image to focus on your chosen product, collection, or blog post. Add details on availability, style, or even provide a review.
Emerging Human Trials Proving Memory Benefits.
Pair text
Standardized dosing = consistency.
Pair text
About
Core Mechanisms
Homeostasis
Homeostasis is the body’s dynamic setpoint—coordinating redox (Nrf2), inflammatory tone, and stress responses to keep systems steady. Balances redox (Nrf2), inflammation, and stress-response.
Activates Nrf2 (HO-1, NQO1, glutathione enzymes).
Pair text with an image to focus on your chosen product, collection, or blog post. Add details on availability, style, or even provide a review.
Emerging human trials show memory benefits.
Pair text
Standardized dosing = consistency.
Pair text
Subheading
Heading
Use this text to share information about your brand with your customers. Describe a product, share announcements, or welcome customers to your store.
Subheading
Mechanisms
Bullet one
Bullett 2
Subheading
Practical Use and Dosing
Use this text to share information about your brand with your customers.
Use this text to share information about your brand with your customers. Describe a product, share announcements, or welcome customers to your store.
Describe a product, share announcements, or welcome customers to your store.
Share information about your shipping rates, return policy or contact information.
Use this text to share information about your brand with your customers. Describe a product, share announcements, or welcome customers to your store.

